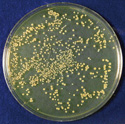

厳重な衛生管理が必須の病院や食品工場など、さまざまな施設で活用されている殺菌システム。
現在はUVランプを利用したタイプが主流ですが、効果を発揮するまでに長い時間がかかるなどの課題を抱えています。
そこで、さらなる実用性を求めて開発されたのが、長年培ったプロフェッショナルカメラマン向けストロボの技術を応用したCOMETのクリアパルス殺菌システムです。
圧倒的に強い紫外線エネルギー
UVランプの数万倍という瞬間紫外線エネルギーを発生させることでDNAを破壊。
さらに近赤外線による熱線破壊とのダブルの効果で、短時間での殺菌を実現します。
人に、コストにやさしいケミカルフリー
薬品や洗剤を使わないため耐性菌をつくらず、残留毒性もないので安心して使用できます。
また、薬品購入も不要で、短時間かつ比較的少ない消費電力なので、ランニングコストを抑えることも可能です。
インフルエンザウイルスを滴下したシャーレにSA-101のユニット単体で照射
試験機関:財団法人北里環境科学センター
- A型インフルエンザウイルス(H1N1)不活化効果試験

検出限界値:6.3TCID50/mL 試験成績書No.北環発21_0043号より
- A型インフルエンザウイルス感染による細胞変性効果

ウイルス非感染細胞MDCK細胞

ウイルス感染細胞(感染4日後)
Bacillus subtilis(芽胞菌)を培地したシャーレにユニット単体で照射して菌を測定(距離50mm)
試験機関:株式会社静環検査センター
- Bacillus subtils(芽胞菌)の殺菌効果試験

- ストロボ光による殺菌効果試験
-
無照射

0.2秒照射

0.8秒照射
Staphylococcus aureus NBRC 12732(黄色ブドウ球菌)の10m3内試験
試験機関:財団法人北里環境科学センター
- 10畳(45m3=3.6m×4.5m×2.7m)の殺菌時間

- 1m3のチャンバー内中央にストロボ光発光管を設置し、黄色ブドウ球菌(SA)菌噴霧器具で10分間噴射(菌液は101000Lairになるように調製)。
- 噴霧停止後、1分間放置して菌の分布を均一化。
- ストロボ光各回数発光後、1分間放置してインピンジャーで2分間捕集し菌数を測定。
- 浮遊菌の殺菌効果試験風景

紫外線に対し強い耐性を持つ黒麹カビに、ストロボ光、UVランプを照射して比較。
ストロボ光はわずか1.4秒で高い殺菌効果、UVランプは5秒照射でも実用性がありません。
この結果、短時間殺菌にはストロボ光が効果的だとわかります。
ストロボ光の殺菌効果
試験機関:財団法人北里環境科学センター
- ストロボ光照射回数と殺菌力

黒麹カビ(Aspergillus niger)にストロボ光を5Hzで照射し生菌数を計測、その殺菌効果を考察
財団法人北里環境科学センター 北環科第0009-2号 表-1より
UVランプの殺菌効果
試験機関:財団法人北里環境科学センター
- UVランプ点灯経過時間と殺菌力

黒麹カビ(Aspergillus niger)に65WUVランプ4灯を点灯し生菌数を計測、その殺菌効果を考察→温度制御のないUV装置は、温度上昇により殺菌線(低圧水銀放電灯の輝線)が減少し、殺菌力が極端に低下。
財団法人北里環境科学センター 北環科第0055-2号 表-6より
Q.どのような細菌に有効ですか?
UVランプの数万倍という瞬間紫外線エネルギーを発生させることでDNAを破壊。
さらに近赤外線による熱線破壊とのダブルの効果で、短時間での殺菌を実現します。
Q.どんな場所に使えますか?
医療施設や介護施設、保育所など、衛生的な環境が求められる場所ならどこでも使えます。詳しくはこんな施設・場所・物にをご覧ください。


